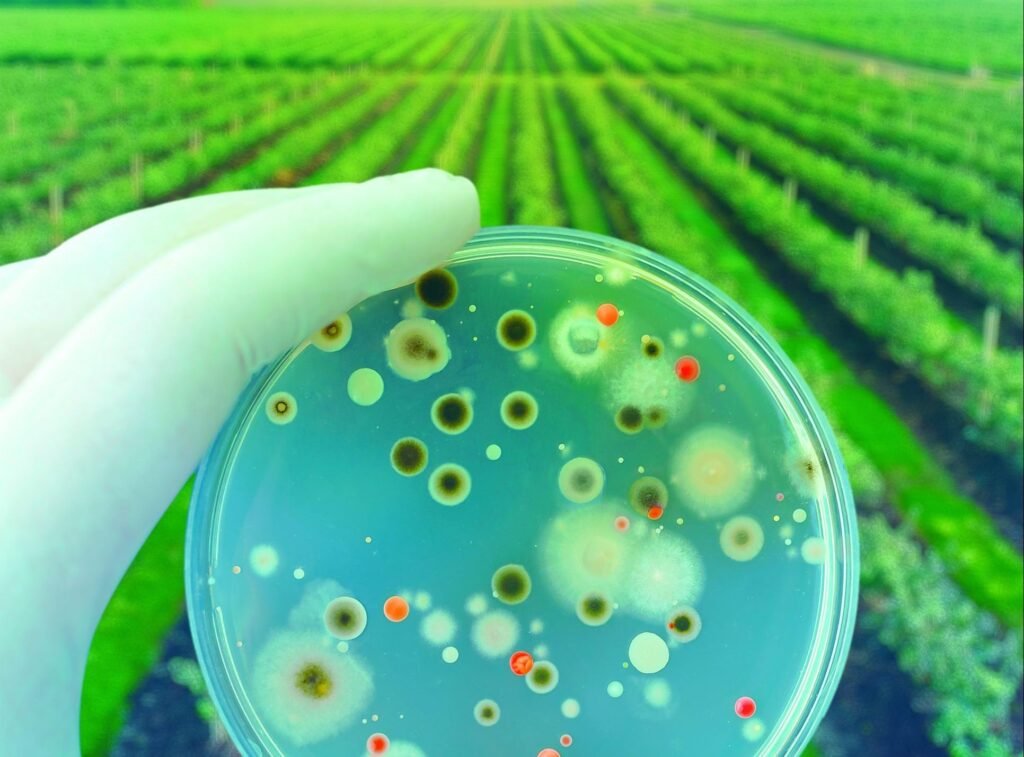

Diagnóstico y conteo de organismos benéficos
En Verantta evaluamos la presencia y cantidad de organismos benéficos en tu cultivo o suelo, brindándote información clave para un manejo integrado más eficiente y sustentable.
¿Qué hacemos?
Identificamos e individualizamos organismos benéficos como depredadores, parasitoides, hongos y bacterias benéficas.
Realizamos conteos poblacionales para conocer el equilibrio biológico en el cultivo.
Entregamos reportes detallados que permiten diseñar estrategias de conservación y liberación de organismos benéficos.
Beneficios para tu producción:
Optimización del Manejo Integrado de Plagas y Enfermedades (MIP).
Reducción de aplicaciones innecesarias de agroquímicos.
Aumento de la biodiversidad y mejor salud del agroecosistema.
Mayor eficacia al usar productos biológicos.
Este servicio te ayuda a fortalecer el control biológico y a mantener un equilibrio natural en tus cultivos, mejorando la rentabilidad y sustentabilidad de tu producción.
